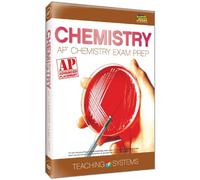
Ap Chemistry Exam Prep

Al momento non ci sono offerte disponibili per la tua ricerca.
Risultati di ricerca
AP CHEMISTRY Prep Guide: Understand Hard Topics the Easy Way with Step-by-Step Explanations & Real Practice Tests | Gain Total Clarity on Chemistry Concepts & Earn a Confident, Well-Earned Score of 5!
Prodotti simili

Chemistry-Ap Exam Prep
72,00 €
amazon-marketplace.it
Spedizione da 5,00 €
Ap Chemistry Exam Prep
199,00 €
amazon-marketplace.it
Spedizione da 5,00 €

AP CHEMISTRY school unit tests & AP test prep book
34,07 €
Amazon.it
Spedizione gratuita

27,20 €
Amazon.it
Spedizione da 2,70 €

AP Chemistry Exam Prep 2026 .: Complete Review of Key Topics, Exam Strategies, and Full-Length Practice Tests for High Scores .
11,53 €
Amazon.it
Spedizione da 2,70 €